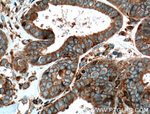
GLT25D1 Antibody in Immunohistochemistry (Paraffin) (IHC (P))

Search
Proteintech
GLT25D1 Polyclonal Antibody
{{$productOrderCtrl.translations['antibody.pdp.commerceCard.promotion.promotions']}}
{{$productOrderCtrl.translations['antibody.pdp.commerceCard.promotion.viewpromo']}}
{{$productOrderCtrl.translations['antibody.pdp.commerceCard.promotion.promocode']}}: {{promo.promoCode}} {{promo.promoTitle}} {{promo.promoDescription}}. {{$productOrderCtrl.translations['antibody.pdp.commerceCard.promotion.learnmore']}}
产品信息
16768-1-AP
种属反应
已发表种属
宿主/亚型
分类
类型
抗原
偶联物
形式
浓度
规格
纯化类型
保存液
内含物
保存条件
运输条件
产品详细信息
Immunogen sequence: MLPGYRDPY HGRPLTKGEL GCFLSHYNIW KEVVDRGLQK SLVFEDDLRF EIFFKRRLMN LMRDVEREGL DWDLIYVGRK RMQVEHPEKA VPRVRNLVEA DYSYWTLAYV ISLQGARKLL AAEPLSKMLP VDEFLPVMFD KHPVSEYKAH FSLRNLHAFS VEPLLIYPTH YTGDDGYVSD TETSVVWNNE HVKTDWDRAK SQKMREQQAL SREAKNSDVL QSPLDSAARD EL (1-231 aa encoded by BC020492)
仅用于科研。不用于诊断过程。未经明确授权不得转售。
生物信息学
蛋白别名: ColGalT 1; Collagen beta(1-O)galactosyltransferase 1; glycosyltransferase 25 domain containing 1; Glycosyltransferase 25 family member 1; gt251; Hydroxylysine galactosyltransferase 1; Procollagen galactosyltransferase 1; unnamed protein product
基因别名: 2810024B22Rik; BSVD3; ColGalT 1; COLGALT1; GLT25D1; PSEC0241; RGD1309002
UniProt ID: (Human) Q8NBJ5, (Mouse) Q8K297
Entrez Gene ID: (Human) 79709, (Rat) 290637, (Mouse) 234407